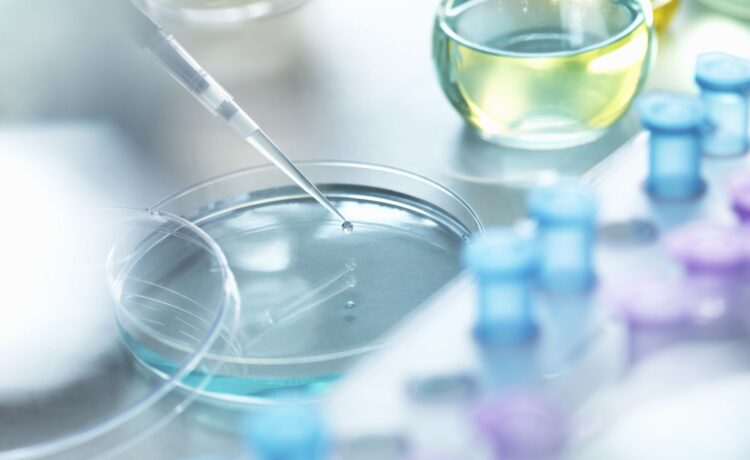

Selecting the right lab accessories is crucial for optimizing laboratory performance. Lab equipment, such as the following plays a pivotal role in achieving accurate and timely results:
- Battery eliminators
- Flasks
- Gel documentation systems
- Hot plates
- Lab coats
- Lenses
- Magnets
- Microscopes
- Safety glasses,
- Test tubes
Lab managers must prioritize high-quality supplies to ensure reliable outcomes and avoid wasting time and resources. Choose only the reliable suppliers to ensure quality. You can visit https://completelabsystems.com/ for the best quality equipment at best prices. Also, they offer proper service backup whenever needed.
Key factors to consider when purchasing lab accessories include:
- Durability
- Precision
- Compatibility with existing equipment
- Ease of use
- Adherence to safety standards.
Making informed decisions in equipment procurement is essential for efficient and effective laboratory operations. Let us discuss a few factors to consider when buying lab equipment.
- Budget
Your budget significantly influences your lab equipment choices. Define your spending limit before shopping and explore suppliers offering competitive prices, promotions, or discounts. However, prioritize quality over cost to ensure reliable equipment.
If budget constraints prevent purchasing, consider leasing lab equipment in San Francisco, which is cost-effective and often includes maintenance. Leasing allows you to access high-quality tools while managing expenses.
- Brand and quality
Research well-known lab equipment brands and read customer reviews to identify reliable options. Established brands may offer quality, but can be expensive and limited to larger labs.
However, emerging brands with advanced technology now provide high-quality, durable, and accessible equipment. Explore these newer options to find cost-effective yet reliable choices for your lab needs.
- New or used equipment
When acquiring lab equipment, you can purchase new or use existing supplies. Buying new materials can be costly, so considering used or re-certified equipment is a budget-friendly alternative.
However, please exercise caution when buying used items at lower prices, as they may have lower quality and require additional spending on repairs and reconditioning.
- Ease of use
Investing in high-quality lab equipment streamlines research, making it more efficient and manageable. Select equipment aligned with your skill level. In understaffed labs, opt for advanced automated options to minimize user intervention.
Avoid overly complex features that can complicate operations prioritize user-friendly equipment that facilitates lab procedures smoothly. Compatibility with your specific research needs is essential for optimal functionality.
- Product features
When choosing lab equipment, compare technical features and specifications among different brands to find the best fit. Assess their value addition, processing capacity, and speed.
Also, consider your lab’s size. Some compact bench-top models offer space efficiency without compromising performance. Ensure the selected equipment aligns with your lab’s capabilities and spatial constraints for efficient and effective operations.
- Warranty and after-sale services
Equipment without a warranty can raise concerns and doubts. Therefore, checking the warranty period and post-purchase support offered before buying is essential.
A reliable product warranty provides peace of mind and can save significant expenses in case of unforeseen issues or defects.
Even seasoned laboratory professionals can make errors when procuring lab equipment. As a lab owner, compromising product quality can jeopardize service quality and result integrity. To ensure you acquire the right equipment, heed the six tips above for making informed purchasing decisions in your lab.